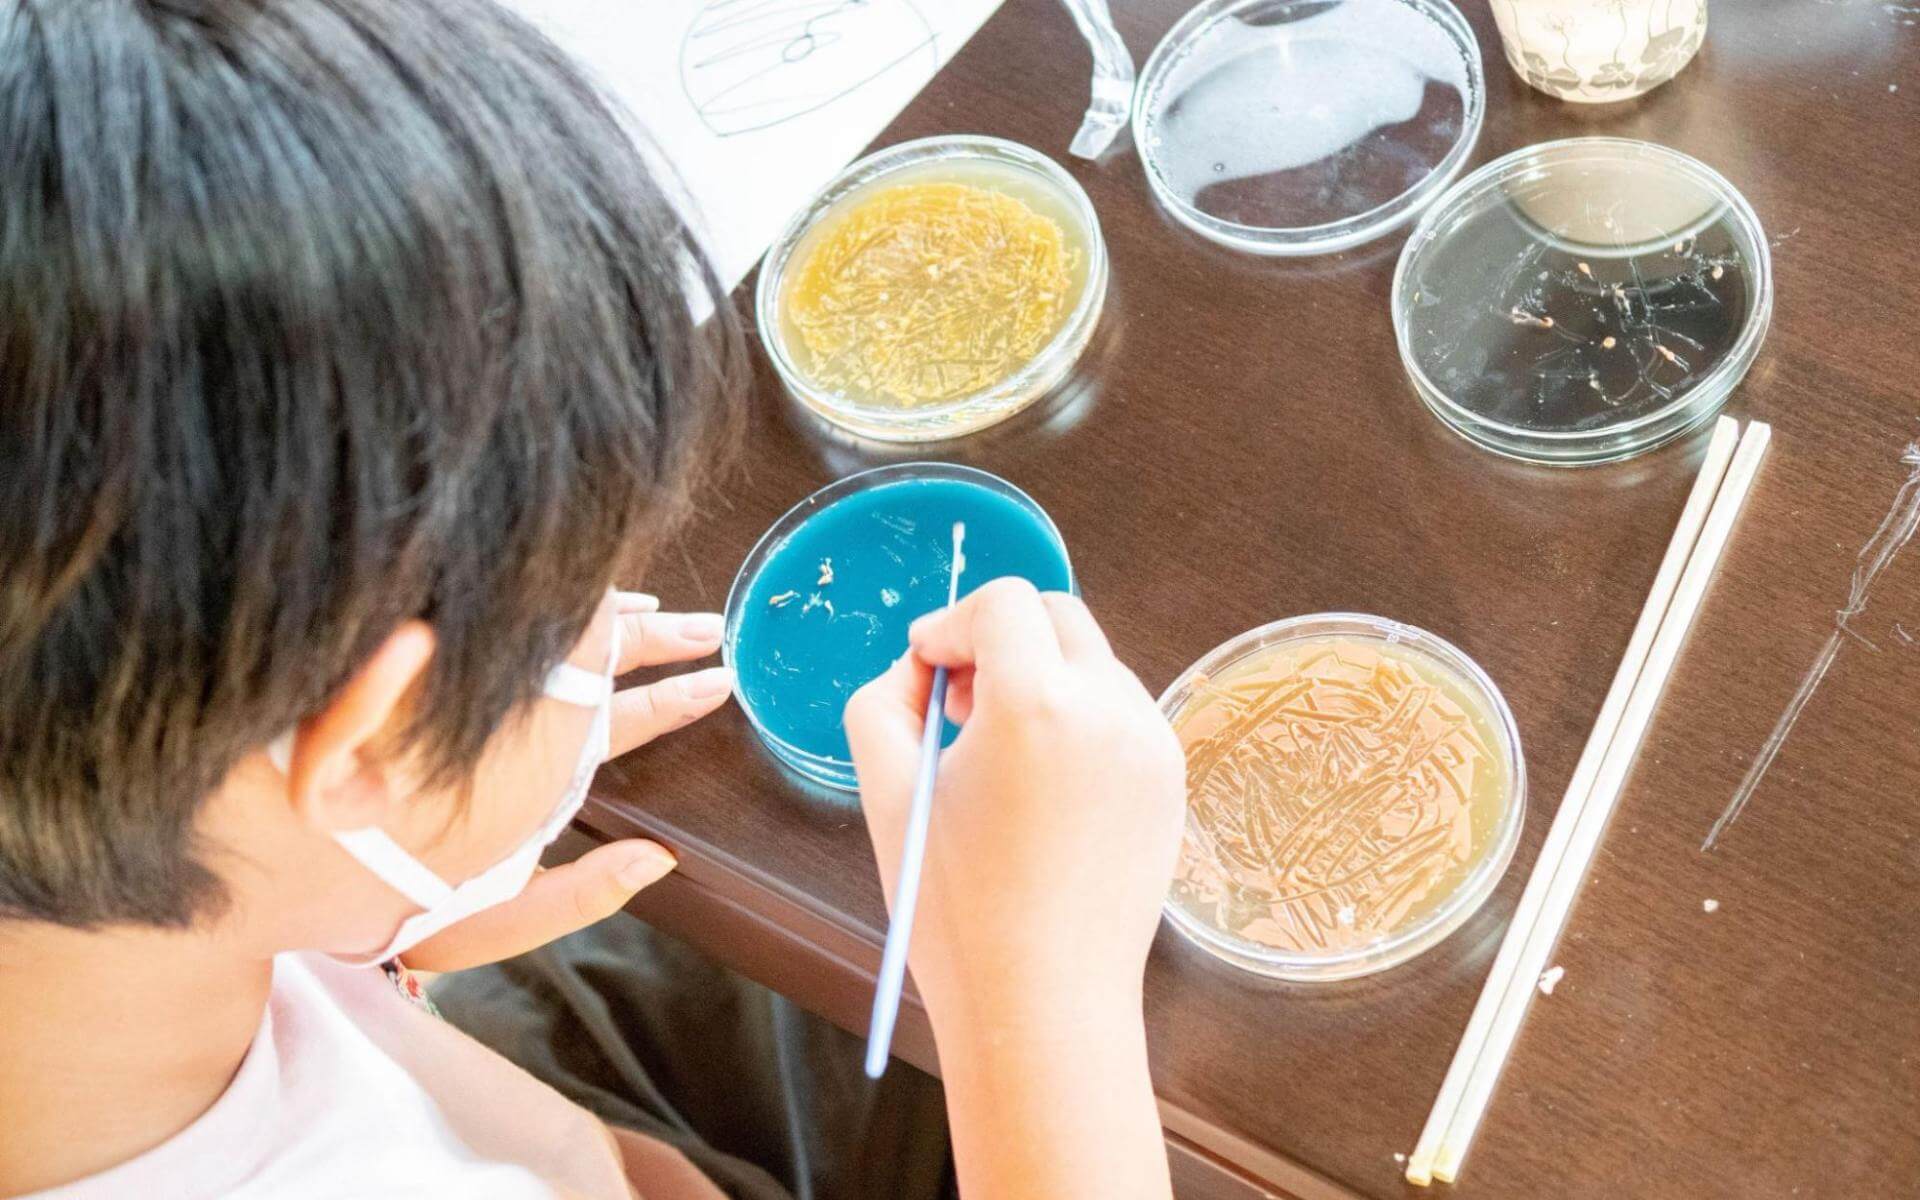

Workshop
- #開催終了
- #誰でもウェルカム
教育におけるDIYバイオハックの可能性を探るべく、京都産業大学生命科学部の川上研究室と市民による培養肉開発コミュニティ「Shojinmeat Project」との共催でイベントを開催。DIYバイオの考え方や手法と、生命倫理という答えの出せない領域に向き合うディスカッションを促すワークの2種類を体験いただける機会です。ぜひ奮ってご参加ください。
2024.10.5 (土) UTC+09:00
14:00 – 18:00 18:00-18:30 交流会
バイオテクノロジーと聞いてどのようなイメージを持つでしょうか?たとえば、遺伝子組み換え技術を利用する作物の品種改良やそれを利用して作られた食品について、あなたはどんな意見を持っていますか?遺伝子を調べることであなたの体や病気の特性が分かるようになり、治療効果の高い薬を選べる病気があります。もしその病気になったら遺伝子検査を受けますか?その意見や判断を持つに至るまでにどのような情報を何から得ましたか?
社会の複雑化とともに、教育プログラムも大きく発展してきています。たとえば、工学的なリテラシーに関しては、プログラミングの授業が一般化したり、3Dプリンターなどの工作機械が使える場もあるなど、実践的・探究的な取り組みが広がっています。
今、生物学的リテラシーに関しても、同様の転機が訪れているのではないでしょうか。バイオテクノロジーの発展は目覚ましいものがありますが(※)、一般的な市民のリテラシーを育む枠組みがないために、企業が開発した商品や国や自治体の規制に関して、市民が自ら情報を精査して判断できているかといえば、まだまだ難しいものがあるといえます。また、気候変動など環境課題が深刻化し、経済活動を根本的に見直さなければならない時代において、施策に直接的に関わるバイオリテラシーを育むことは、あらゆる事業において事象の解像度を高め、学際的取り組みも促進させるでしょう。学校教育においても、バイオリテラシーに関わるプログラムの可能性を探究できるタイミングです。
※ たとえば、30年前はヒトゲノム解析に3000億円かかっていたのが、今ではたった10万円でできるように、技術の発展に伴って、比較的安価にバイオテクノロジーに関われる時代になっています。世界的にも新規参入が目覚ましく、2022年時点でおよそ10兆円規模に達しており、今後も年平均成長率(CAGR)が8%~12%に達すると予測されているようです。日本においても、2019年に発表された「バイオ戦略」に基づき、特にヘルスケア・医療分野、食料・農業分野、そして環境分野へのバイオ関連予算が増額されており、2021年には約350億円だった「バイオ戦略」に関連する政府予算は、2023年度には約1,000億円とされ、この分野でのイノベーションが推進されています。(参照:内閣府ホームページ)


2022年にFabCafe Kyotoで開催された子ども向けのバイオワークショップの様子
オランダで1994年から活動する研究機関の「Waag」では、バイオテクノロジーは市民レベルのリテラシーが最も低いテクノロジーのひとつであるとし、研究者・教育者・アーティストが協働することで、市民のためにバイオテクノロジーを開くプログラムを実施してきています。(中でもBioHack Academyは3か月間の集中コースとして2015年から毎年開催されています(参考:BioHack Academy 2022レポート)。Waagなどで実践してきた手法のひとつが「DIYバイオ」で、一般家庭で調達できる機材や手法でバイオテクノロジーを実践するという考え方・手法です。安全に実験を行う知識と環境を整えることで、専門機関に行かずとも、スーパーやドラッグストアで購入できるような材料を使いながら、バイオの世界を探究し、市民自ら知識や技術を深める市民科学のアプローチのひとつです。
教育現場には大掛かりなバイオ実験ができる施設はありません。一方で、一般市民でも入手可能な機材も増えてきているうえ、これまで様々な研究者や市民が積み重ねてきたDIYバイオの考え方や手法を用いることで、実践可能な方法も増えているのです。

2022年にバイオアーティストGeorg Tremmelを講師に招いて開催された SPCS Season1「What Is Life?」より
今回のイベントでは、具体的に授業で取り入れうる「DIYバイオ」の考え方や手法と、生命倫理という答えの出せない領域に向き合うディスカッションを促すワークの2種類を体験・ご紹介します。学校教育のプログラムとしてはもちろん、成人向けの教育としても活用できるでしょう。ぜひ奮ってご参加ください。
市民による培養肉開発コミュニティ「Shojinmeat Project」による、培養肉実験(体験版)を実施します。Shojinmeat Projectはバイオの民主化を掲げてオープンソースで培養肉を作ろうという市民コミュニティで、羽生雄毅さんによって2014に立ち上げられ、多面的な活動やだれもがアクセスできる知識を生み出してきています。今回のワークでは、Shojinmeat Projectのメンバーである杉崎麻友さんによる、細胞を使った培養肉実験を体験いただきながら、学校教育におけるDIYバイオの可能性をご紹介します。

バイオテクノロジーと一言でいっても、遺伝子工学から発酵技術、バイオセンサーなど、さまざまなものがあります。今回は、難しい議論となりやすい生命科学の視点でディスカッションの機会を設けます。ファシリテーターは、京都産業大学 生命科学部産業生命科学科准教授の川上雅弘さん。彼の研究室で作った生命科学が関わる生命倫理のテーマをディスカッションするためのカード型教材を用いて、普段ディスカッションしにくいテーマについて意見を交わしてみましょう。
Building Dialog for Genome editing technology(ゲノム編集カードゲーム)ー 京都産業大学 生命科学部 川上研究室開発

川上研究室によって作られた「ゲノム編集」に関するカードゲーム。このカードゲームでは、プレイヤーは、研究者や神父、消費者など様々な立場が与えられ、あるテーマについて意見を出し合います。普段はあまり考えることがない「ゲノム編集」について、自分とは異なる立場で意見を考え、そして対話する機会を皆さんに提供します。ゲノム編集技術は社会の中で大きなキーワードとなっているなかで、このような技術について理解を深め、自分自身の考えを持つきっかけとすることを目的に作られました。
- 探究型学習のあり方や手法を探っている教育者や教育関係者の方
- 科学分野における新たな学びのあり方を考えている理科教諭の方
- 科学コミュニケーターや科学館などで企画を担当する方
- これからの科学教育の指針を設計する自治体、教育委員会の方

SPCS(スピーシーズ)は、プロトタイピングしながら、生態系のメカニズムを探究し、自然をコントロールしないデザインや、人間以外の種との創造的な共創関係を探究するコミュニティです。
自然科学、デザイン、アート、エンジニアリング、文化などが複合的に混ざり合った活動を領域横断で取り組むことで、技術や知識を開き、価値観や手法をアップデートすべく、活動しています。
-
川上 雅弘
京都産業大学, 生命科学部 産業生命科学科 准教授
2006年近畿大学大学院農学研究科博士課程修了。大学院では畜産学研究室で体細胞クローンブタの作出研究に取り組む。この中で、実験研究の面白さと同時に、生命科学が関わる生命倫理、科学技術の進展から生まれる社会課題に取組む重要性を感じる。大学院修了後に京都大学人文科学研究所の研究室で、科学コミュニケーションや生命倫理、研究ガバナンスの分野の研究や教育実践を開始。京都大学iPS細胞研究所、大阪教育大学科学教育センター、奈良先端科学技術大学院大学教育推進機構を経て2019年より現職。生命科学が生む新しい技術や概念を社会と共有し、そのあり方を考えていきたい。
2006年近畿大学大学院農学研究科博士課程修了。大学院では畜産学研究室で体細胞クローンブタの作出研究に取り組む。この中で、実験研究の面白さと同時に、生命科学が関わる生命倫理、科学技術の進展から生まれる社会課題に取組む重要性を感じる。大学院修了後に京都大学人文科学研究所の研究室で、科学コミュニケーションや生命倫理、研究ガバナンスの分野の研究や教育実践を開始。京都大学iPS細胞研究所、大阪教育大学科学教育センター、奈良先端科学技術大学院大学教育推進機構を経て2019年より現職。生命科学が生む新しい技術や概念を社会と共有し、そのあり方を考えていきたい。
-
杉崎 麻友
Shojinmeat Project (Forsea Foods | BD Manager)
北海道大学農学部卒、東京大学院修士修了。分子細胞生物学が専門領域。
「細胞ちゃんを愛でたい」そんな想いを胸に、DIYで培養肉の開発に挑む有志団体
Shojinmeat Projectにメンバー入り。普段はイスラエルのスタートアップで事業開発と研究員をやっています。
Blog:るるまゆの実験ノート
記事:純肉(clean meat)が切り拓く、未来の細胞農業 -Shojinmeat プロジェクト 杉崎 麻友北海道大学農学部卒、東京大学院修士修了。分子細胞生物学が専門領域。
「細胞ちゃんを愛でたい」そんな想いを胸に、DIYで培養肉の開発に挑む有志団体
Shojinmeat Projectにメンバー入り。普段はイスラエルのスタートアップで事業開発と研究員をやっています。
Blog:るるまゆの実験ノート
記事:純肉(clean meat)が切り拓く、未来の細胞農業 -Shojinmeat プロジェクト 杉崎 麻友 -
浦野 奈美
SPCS / FabCafe Kyoto
大学卒業後ロフトワークに入社。渋谷オフィスにてビジネスイベントの企画運営や日本企業と海外大学の産学連携のコミュニティ運営を担当。2020年にはFabCafe Kyotoのレジデンスプログラム「COUNTERPOINT」の立ち上げと運営に従事。また、FabCafeのグローバルネットワークの活動の言語化や他拠点連携の土壌醸成にも奔走中。2022年からは、自然のアンコントローラビリティを探究するコミュニティ「SPCS」の立ち上げと企画運営を担当。大学で学んだ社会保障やデンマークのフォルケホイスコーレ、イスラエルのキブツでの生活、そして、かつて料理家の森本桃世さんと共催していた発酵部活などが原体験となって、場の中にカオスをつくることに興味がある。
大学卒業後ロフトワークに入社。渋谷オフィスにてビジネスイベントの企画運営や日本企業と海外大学の産学連携のコミュニティ運営を担当。2020年にはFabCafe Kyotoのレジデンスプログラム「COUNTERPOINT」の立ち上げと運営に従事。また、FabCafeのグローバルネットワークの活動の言語化や他拠点連携の土壌醸成にも奔走中。2022年からは、自然のアンコントローラビリティを探究するコミュニティ「SPCS」の立ち上げと企画運営を担当。大学で学んだ社会保障やデンマークのフォルケホイスコーレ、イスラエルのキブツでの生活、そして、かつて料理家の森本桃世さんと共催していた発酵部活などが原体験となって、場の中にカオスをつくることに興味がある。
Organizers
-
京都産業大学川上研究室
-
Shojinmeat Project
-
SPCS
-
14:00-14:15
-
イントロダクション(SPCS 浦野奈美)
・企画趣旨、企画メンバー紹介 -
14:15-14:30
-
生命倫理教育とDIYバイオハックの可能性(京都産業大学, 生命科学部 産業生命科学科 准教授 川上 雅弘)
-
14:30-16:30
-
細胞培養ワークショップ(Shojinmeat Project 杉崎 麻友)
・Shojinmeat Projectの活動とミッション(約20分)
・細胞培養ワークショップ(約1.5時間)
・DIYBioHackの環境作り
・魚または有精卵の解剖
・培地の準備 -
16:30-18:00
-
ディスカッション
・「Building Dialog for Genome editing technology(ゲノム編集カードゲーム)」使ってディスカッション(約1時間)
・食とテクノロジーについてディスカッション(約30分) -
18:00-18:30
-
交流
-
日時
-
2024.10.5 (土) 14:00 – 18:00 18:00-18:30 交流会 UTC+09:00
-
会場
-
FabCafe Kyoto (MTRL KYOTO)
〒600-8119 京都府京都市下京区本塩竈町554
■電車でのアクセス
JR京都駅から徒歩20分
京都市営地下鉄烏丸線五条駅から徒歩10分
阪急電鉄京都線河原町駅から徒歩15分
京阪電鉄清水五条駅から徒歩5分
■バスでのアクセス
京都駅から4・17・205号系統 五条河原町下車徒歩3分
※駐車場はありません。近隣の施設をご利用ください。
Google mapで開く -
参加費
-
無料
-
定員
-
20名
-
オーガナイザー
-
Organizers: 京都産業大学川上研究室, Shojinmeat Project, SPCS


